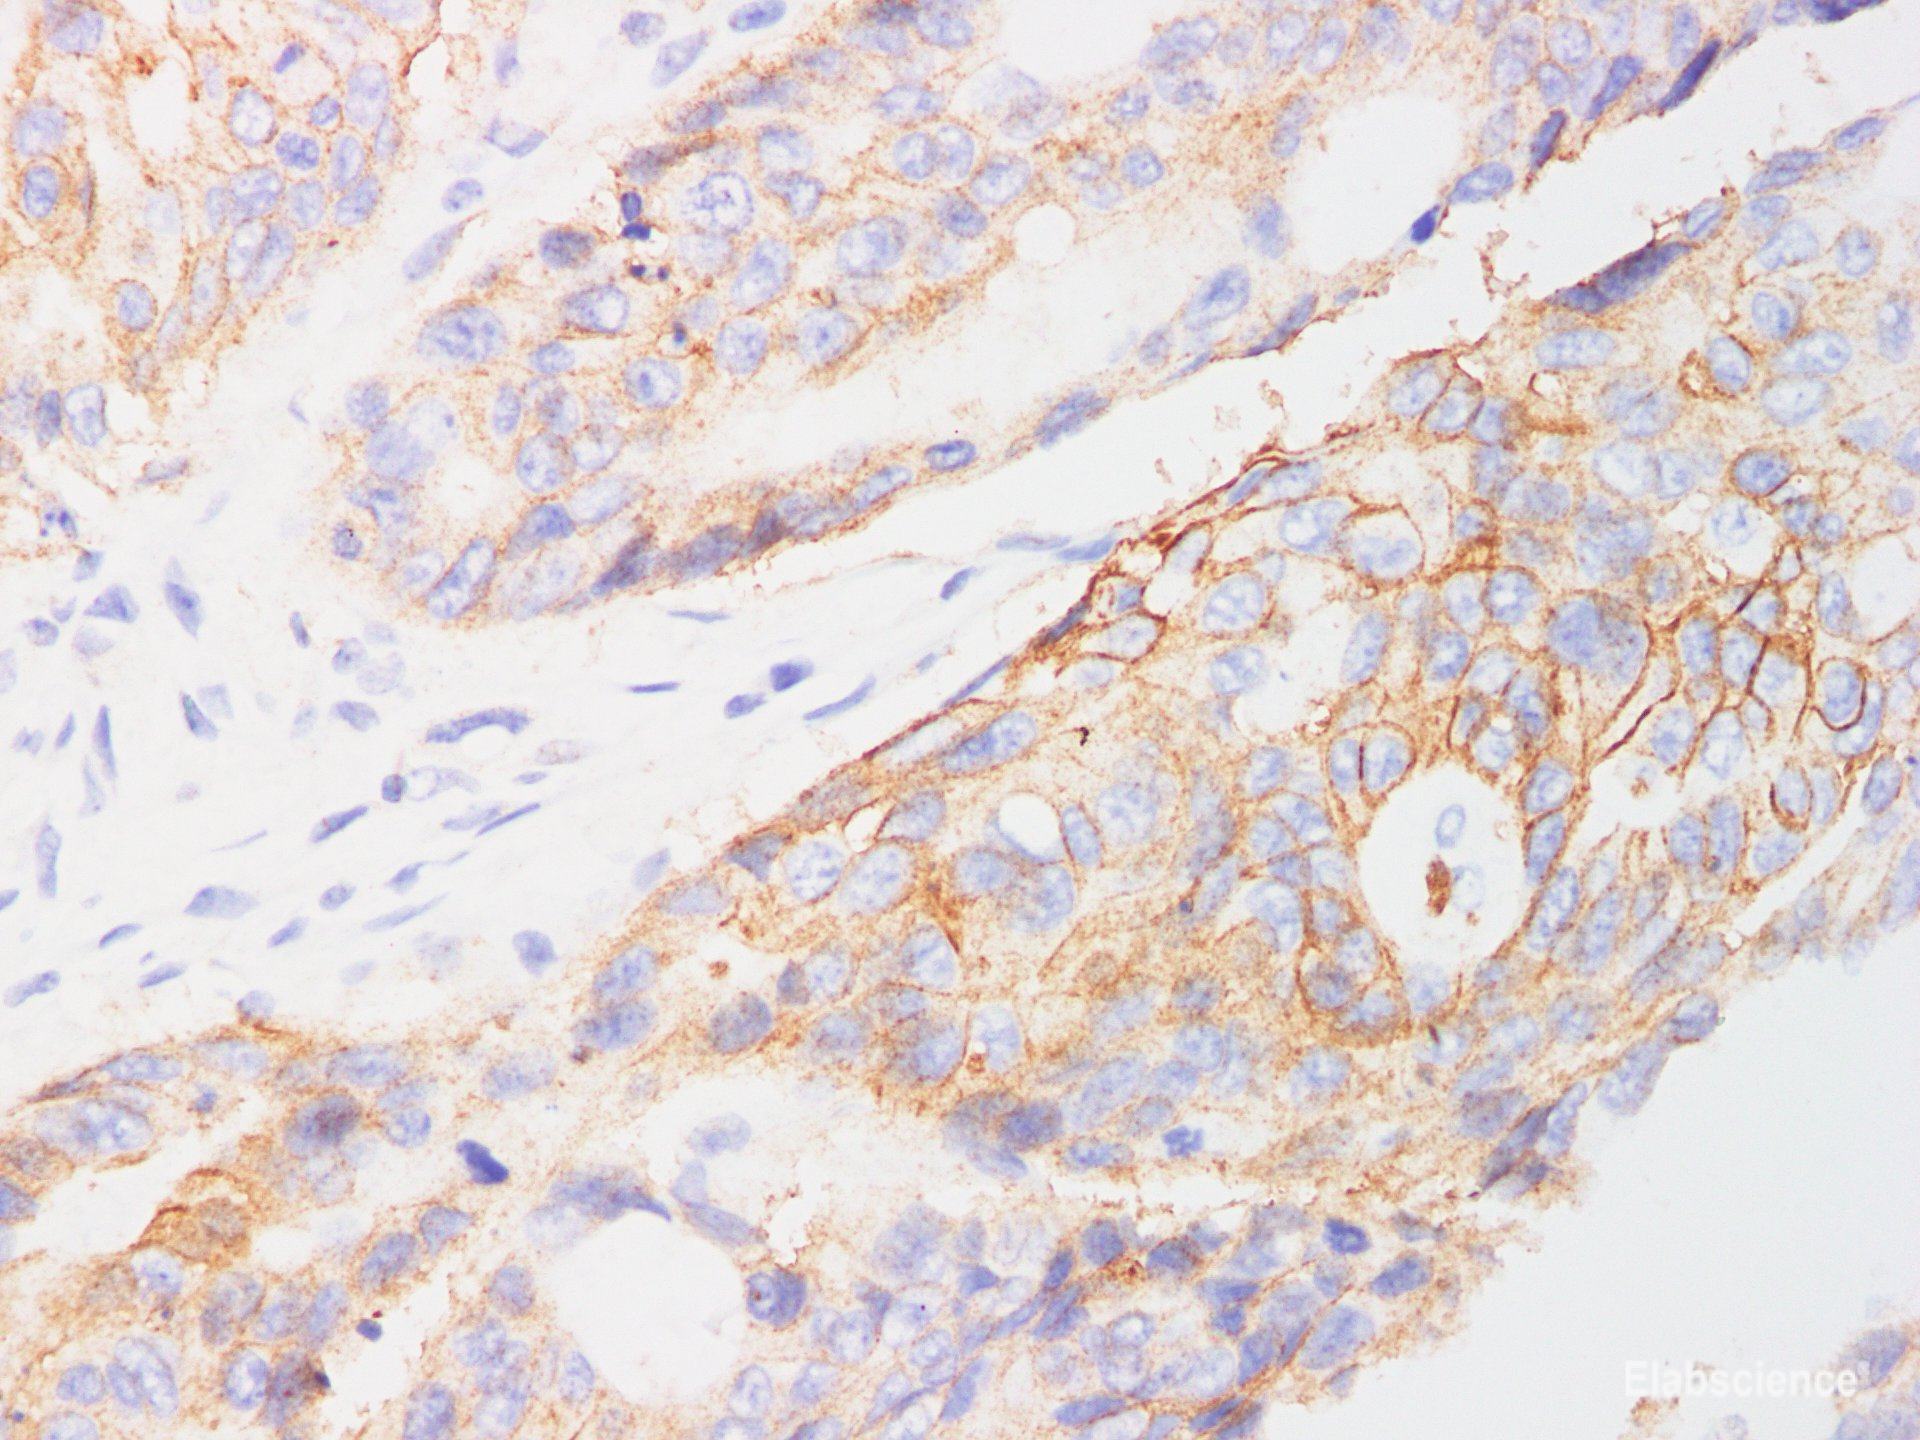
Immunohistochemistry of paraffin-embedded Human colon cancer using EpCAM Polyclonl Antibody at dilution of 1:200.

Elabscience
SKU:E-AB-40305
EpCAM Polyclonal Antibody
EpCAM Polyclonal Antibody
Couldn't load pickup availability
EpCAM Polyclonal Antibody
The EPCAM Polyclonal Antibody is a highly specific and reliable tool designed for the detection and analysis of Epithelial Cell Adhesion Molecule (EPCAM) in various biological samples. This antibody is produced using advanced immunization techniques, ensuring high affinity and sensitivity towards EPCAM.
With its exceptional performance, this polyclonal antibody offers a wide range of applications in research and diagnostics. It can be utilized in immunohistochemistry (IHC), immunofluorescence (IF), western blotting (WB), and flow cytometry (FC) techniques.
The EPCAM Polyclonal Antibody exhibits excellent specificity, enabling accurate identification and quantification of EPCAM expression in different tissues and cell types. Its robustness and consistency make it an ideal choice for studying EPCAM-related processes, such as cell adhesion, migration, and signaling pathways.
This antibody is manufactured under strict quality control measures, ensuring batch-to-batch consistency and reproducibility. It is supplied in a ready-to-use format, allowing for convenient and efficient experimental procedures.
In summary, the EPCAM Polyclonal Antibody is a valuable tool for researchers and clinicians seeking to investigate the role of EPCAM in various biological processes. Its high specificity, reliability, and versatility make it an indispensable asset in the field of molecular biology and biomedical research.
Share